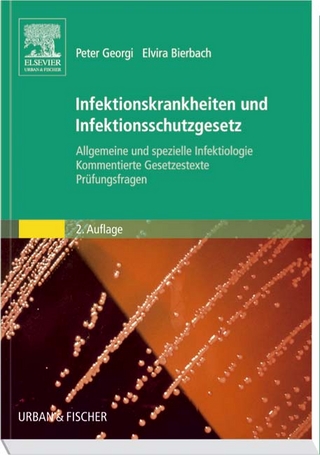
Infektionskrankheiten und Infektionsschutzgesetz

Repetitorium für den psychotherapeutisch orientierten Heilpraktiker und den psychologischen Berater zur Ausbildungsbegleitung, Prüfungs- und..
Buch
2005
|
Lehmanns
ISBN: 9783865410962
CHF 20,85 (inkl. MwSt)
- Titel erscheint in neuer Auflage